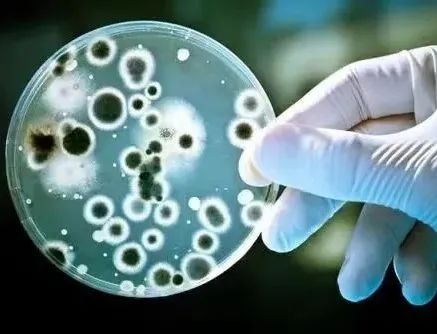
图片

【专业解读】药物制剂专业
2025-06-06


树德为本 技能立身
2025
福建华夏高级技工学校
技能升学班(职教高考或高技升学)
职教本科升学实验班
学制:三年
医药卫生类
01
专业介绍
药物制剂专业为地方经济社会发展、现代化中医药事业和健康产业发展,培养德智体美劳全面发展的社会主义药学事业的建设者。
本专业人才具备药物制剂方面的基础理论、基本知识和基本技能,具有“知识刻苦专研、技能求真务实”精神、创新创业意识和社会服务能力,能在药物研发、生产、检验、流通、使用和管理等领域,从事药物制剂的研发、生产、质量控制、技术创新、药品管理及指导药物合理应用等方面工作的高素质应用型人才。



主干课程
公共基础课(语数英政)、解剖学基础、生理学基础、药理学基础、药品商品营销、药店零售及实训、药物检验技术、药物制剂生产技术、药物化学、生药学基础、医学基础、药事法规等。

教学设施
药剂实训基地建有药剂实验实训室、模拟药房实训室等各种配套设施,可供学生进行专科药剂技能操作训练和综合实践技能训练,能满足药剂专业的实训教学。



就业方向


本专业毕业生主要在制药企业、药品营销企业或医院等单位,从事调配处方、配制制剂、药品质量检测与贮存保管、药品销售的市场开发与经营等业务工作。